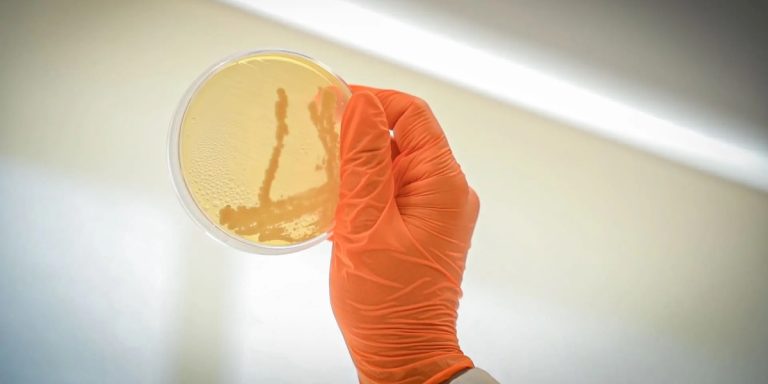
bioprospect microorganismo

bacterias

Salmonela, listeria… ¿cómo evitar las intoxicaciones ‘escondidas’ en nuestra nevera de playa?
Innovaspain
12 agosto, 2025

Luz solar contra bacterias: una «frontera apasionante» entre vida y muerte
José Tomás Palacín
22 julio, 2025

La lucha para acabar con la «superbacteria» que resiste a los antibióticos
José Tomás Palacín
3 abril, 2025

Morty: los microorganismos que reparan hormigones
José Tomás Palacín
13 enero, 2025

El “nanokiller” inteligente que mata bacterias y hongos
José Tomás Palacín
27 mayo, 2024

Javier Carrera: “Con esta plataforma somos capaces de simular millones de antibióticos”
Gabriela Martínez
24 julio, 2020

Premio Explorer al emprendimiento femenino para un proyecto biotecnológico de la UC3M
Pablo Garcinuño
25 noviembre, 2019

La mexicana que lucha por Cuatro Ciénegas, uno de los oasis más antiguos del planeta
Gabriela Martínez
22 octubre, 2019

“La resistencia a los antibióticos no es solo un problema hospitalario”
Innovaspain
5 agosto, 2019

Al descubierto las tácticas grupales de las bacterias para protegerse de los antibióticos
Innovaspain
19 diciembre, 2018

Científicos argentinos avanzan en la ‘receta’ genética para el desarrollo de biofármacos
Innovaspain
10 octubre, 2018